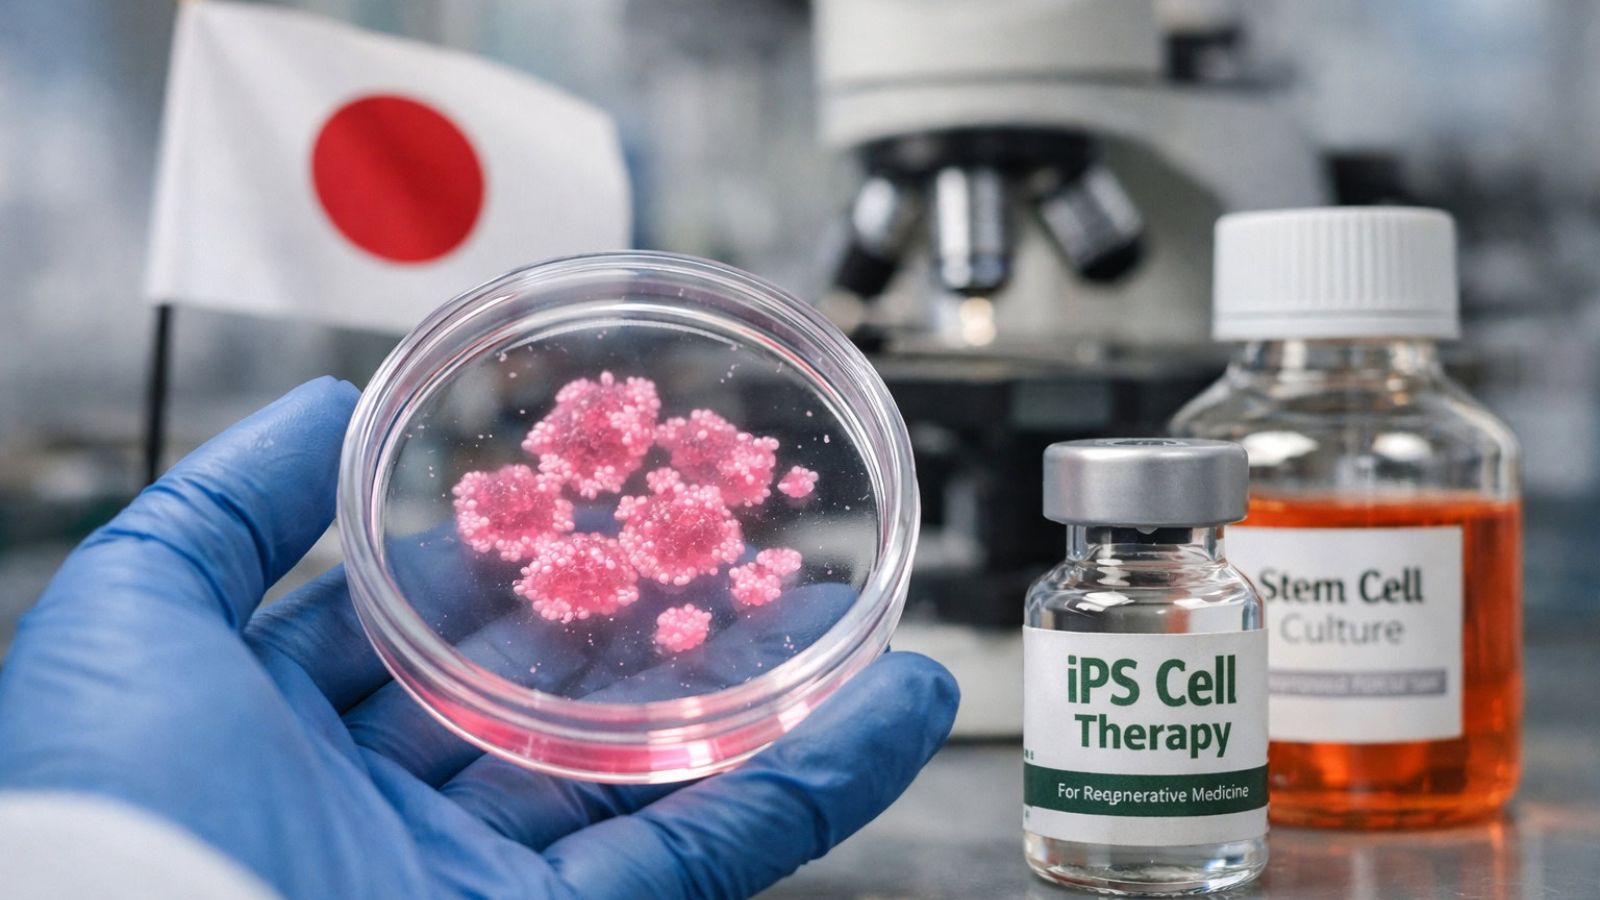
Cellule iPS, il Giappone approva i primi prodotti

Le cellule iPS, ovvero le cellule staminali pluripotenti indotte, hanno appena raggiunto un traguardo che molti ricercatori aspettavano da anni.…
L’articolo Cellule iPS, il Giappone approva i primi prodotti proviene da TecnoAndroid.
Go to Source
Author: Denis